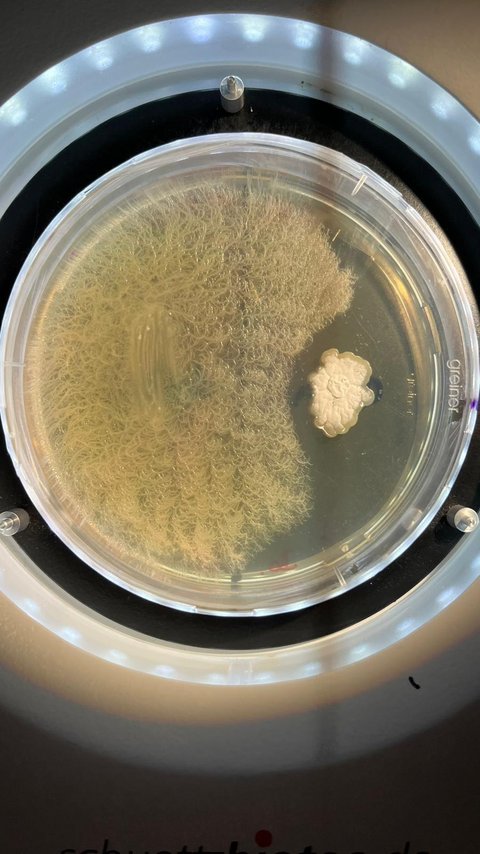
Antibiotikaproduktion in der Agarplatte

Labor für Bioverfahrenstechnik
Dieses Labor wurde im Februar 2008 eröffnet. Die hier veröffentlichte Laborbeschreibung stellt den Betriebszustand des Labors für Bioverfahrenstechnik seit dem Jahr 2024 dar. Für nähere Informationen bezüglich der Laborhistorie zwischen den Jahren 2008 und 2024 wenden Sie sich bitte an die Laborleitung.
Das Labor für Bioverfahrenstechnik
Dieser einschneidende Wandel im Jahre 2024 und unser Umgang damit lässt sich durch folgendes Zitat von Stanislaw Jerzy Lec aus dessen Buch „Unfrisierte Gedanken“ sehr treffend beschreiben:
„Hinter jeder Ecke lauern ein paar Richtungen“
In diesem Sinne möchten wir Sie dazu einladen, uns in der Zukunft um ein paar weitere (hoffentlich etwas weniger ausgeprägte) Ecken zu begleiten und neue spannende Richtungen gemeinsam zu entdecken!
Assoziierte Module bzw. Labore:
Anlagenplanung, Terrestrische Systeme, Umweltmanagement (Umwelt- und biotechnologisches Ressourcenmanagement), Bioreaktoren (Bioverfahrenstechnik I), Vertiefungslabor Environmental Engineering, Angewandte Wärme- und Stoffübertragung (Bioverfahrenstechnik II), Abfalltechnik, Biogene Energiegewinnung und Management erneuerbarer Energien
Schwerpunkte des Labors
Schwerpunkt 1
Die fermentative Produktion von Getränken
Das Labor für Bioverfahrenstechnik ist seit 2025 Ostfalia-weit der erste offizielle gemeldete Lebensmittelproduzent, was Studierenden die Möglichkeit eröffnet, in Eigenverantwortung die Prozesskette der fermentativen Getränkeproduktion in einem Semesterzyklus vollständig zu durchlaufen.
Diese Prozesskette beinhaltet neben der eigentlichen Prozesstechnik auch steuerlich-rechtliche Aspekte, die Einhaltung und Dokumentation von Hygienestandards gemäß des vorliegenden Hygienekonzeptes, die Planung und Durchführung des eigentlichen Prozesses, die zugehörige vollumfassende prozessanalytische Bewertung sowie (last but not least) das zugehörige Vermarktungskonzept des fertigen Produktes unter Berücksichtigung des sozialen Aspektes der Produktion von konsumfähigem Alkohol.
Somit bietet dieses Ausbildungslabor die einzigartige Möglichkeit, bereits im Studium eine vollumfassend interdisziplinäre und anspruchsvolle Prozesskette organisatorisch eigenverantwortlich vom Rohstoff bis zum fertigen Produkt zu durchlaufen, und zwar unter Berücksichtigung aller organisatorisch-rechtlich-bürokratischen Randbedingungen, die ein Prozess der Lebensmittelproduktion mit sich bringt. Somit stellt dieser Laborschwerpunkt eine hervorragende Vorbereitung für kommende berufliche Herausforderungen dar.
Schwerpunkt 2
Das Umweltmonitoring
Auch wenn sie mit dem bloßen Auge nur schwer zu erkennen sind - Kleinstlebewesen und ihre Reaktionen auf Umwelteinflüsse sind ein wichtiges Element im Umweltmonitoring.
Das Labor für Bioverfahrenstechnik setzt diese Methodik (neben zahlreichen weiteren Anwendungen und Versuchen) interdisziplinär als beispielhaften Handshake zwischen den Modulen „Terrestrische Systeme“ und „Aquatische Systeme“ ein, da Bodenkontaminationen und Altlasten häufig erst im Rahmen von Trinkwasseranalysen erkannt werden. Ein Bodenmonitoring benötigt somit nahezu immer eine fachliche Interaktion mit einem Gewässermonitoring.
Auch wenn die Arbeit mit Daphnien nicht unter das Tierschutzgesetz fällt und somit nicht als Tierversuch gilt, ist der Umgang mit Lebewesen ähnlich wie die Produktion von Lebensmitteln höchst verantwortungsvoll, was den Studierenden im Rahmen der Ausbildungslabore konsequent vermittelt wird und somit signifikant zur fachlichen Reife Hand in Hand mit der persönlichen Entwicklung einer akademischen Verantwortung beiträgt.
Schwerpunkt 3
Die verfahrenstechnische Produktaufbereitung
Ohne die verfahrenstechnische Einengung von Produktmatrizes (das sogenannte „Downstreaming“) ist die Nutzung prozesstechnisch hergestellter Produkte häufig wirtschaftlich nicht möglich.
Das Labor für Bioverfahrenstechnik vermittelt diesbezüglich unter anderem Fachwissen in den Bereichen Destillation, Absorption und Extraktion.
Schwerpunkt 4
Die Prozessanalytik
Ohne passende Analytik keine Prozessbewertung; als Beispiel für die zahlreichen prozessadaptierten analytischen Methoden im Labor für Bioverfahrenstechnik zeigen wir hier stellvertretend unseren GC-MS, mit dem wir ein analytisches Spektrum von flüchtigen organischen Säuren bei der Biogasproduktion bis hin zu Aromastoffen in der Getränkeproduktion bis in den geringsten Spurenbereich hinein erfassen können.
Schwerpunkt 5
Die Technologie von Bioreaktoren
Das Labor für Bioverfahrenstechnik scheut bei der Arbeit mit Bioreaktoren keinen Maßstab. DIe Laborhistorie von 2008 bis 2024 war sinnbildlich für die vorhandene Kompetenz in diesem fachlichen Metier und ausgehend von der Agarplatte bis hin zum 2000m3 fassenden Biogasfermenter ist im Fachspektrum auch heute und in der Zukunft noch alles dabei; denn wenn es spannend sein soll, zählt nicht allein die Größe. Natürlich ist es einerseits spektakulär, in einem Biogasfermenter während dessen Revision die Rührwerkstechnik zu begutachten. Andererseits ist es mindestens genauso spannend, in einer Agarplatte das Verhalten antibiotikaproduzierender Mikroorganismen nachzuvollziehen. Für eine gesicherte Zukunft brauchen wir nämlich nicht nur verlässliche regenerative (Bio)energie, wir brauchen auch nachhaltig produzierte Lebensmittel und Medizinprodukte – all dies sind gemeinsam mit unseren Partnern die „Spielwiesen“ der Bioverfahrenstechnik.
Einblicke in das Labor

Ansprechpersonen
Laborleitung
Wissenschaftliche Mitarbeitende
-
Dipl.-Ing. M.B.A Silvia Drescher-Hartung
